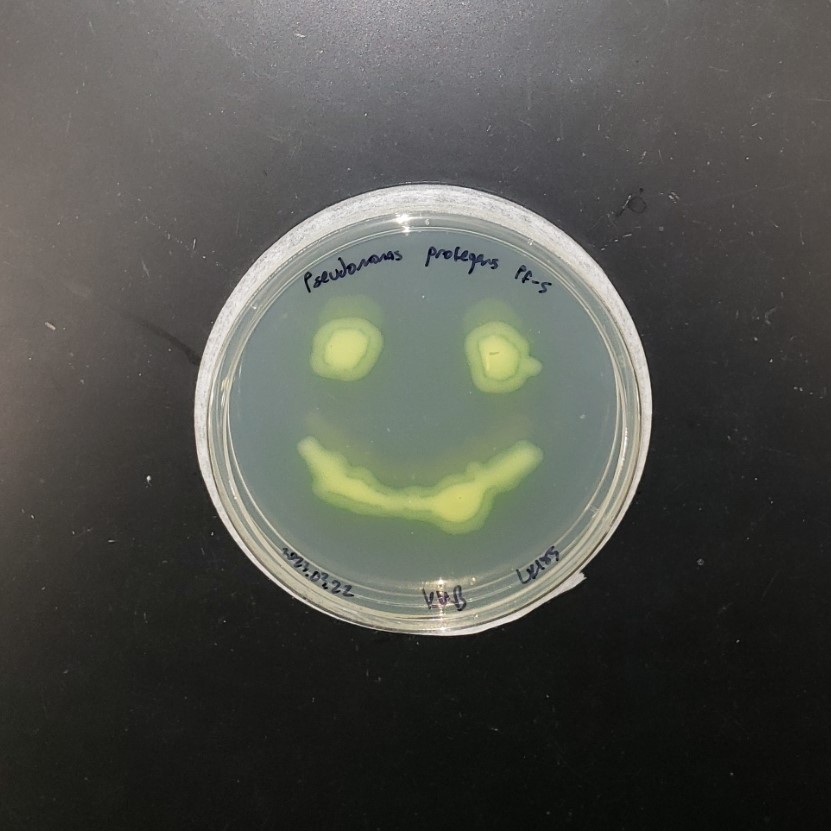
cover image

JESSEE SVOBODA — HTGAA Spring 2026

About me
Bioengineering postdoc researching the effects of genetically modified bacteria on soil microbiota. i love cyanobacteria! 💚 i’m interested in biomanufacturing with photosynthetic microbes.
Contact info
Homework
- Week 1 HW: Principles and Practices
- Week 1 HW: Principles and Practices version2
- Week 2 HW: Read, Write, Edit DNA
- Week 2 HW: Read, Write, Edit DNA Version2
- Week 3 HW: Lab Automation
- Week 4 HW: Protein Design Part I